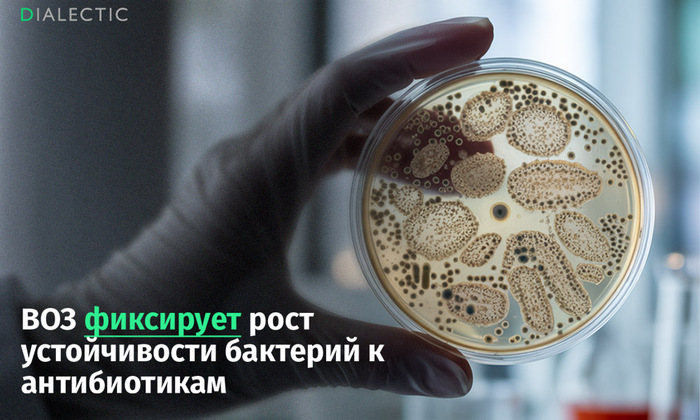
ВОЗ: устойчивость к антибиотикам угрожает миллионам жизней по всему миру

Misha - Топ инди, выпуск #9
«Misha » — это лёгкая бесплатная игра в жанре dress-up, похожая на тамагочи, но живущая прямо на экране вашего компьютера.
Разработчики начали её как паузу от более крупного проекта, но так увлеклись Мишей, что решили довести игру до совершенства. Они хотят, чтобы игрокам захотелось запускать её каждый день и держать поверх всех окон.
Они постарались сделать плавную и выразительную анимацию, гибкую настройку интерфейса и максимально удобное управление. Особенно важно: в «Мише» нет «перекрасов» — то есть предметов, отличающихся лишь цветом. Все вещи нарисованы с нуля и уникальны. Ни в текущей версии, ни в релизе вы не увидите ни одного просто перекрашенного элемента.
Сейчас они завершают финальную доработку и добавляют достижения. Релиз запланирован на 24 октября, и в игре будет:
Более 100 оригинальных предметов для кастомизации Миши
4 темы оформления интерфейса
13 анимаций (или «движений»)
Множество улучшений, предложенных самими игроками
Команда будет рада, если вы попробуете «Мишу»! Все идеи и найденные баги можно присылать в Discord.
💬 Discord: https://discord.gg/D4YdjVWzer
А как же помакать горбушку...
Интересная форма для зажарки яиц на Али, на Яндекс Маркете
ВОЗ: устойчивость к антибиотикам угрожает миллионам жизней по всему миру
Всемирная организация здравоохранения (ВОЗ) заявляет, что мир столкнулся с глобальным кризисом устойчивости бактерий к антибиотикам, который угрожает современной медицине и уносит миллионы жизней. Согласно недавнему докладу организации, в 2023 году каждый шестой случай бактериальной инфекции уже не поддавался лечению стандартными препаратами.
Устойчивость к некоторым видам антибиотиков превысила 40%, а в странах Африки этот показатель достиг 70%. Масштабы проблемы подтверждаются независимыми исследованиями. По данным медицинского журнала The Lancet, уже сейчас 1,27 миллиона смертей в год напрямую связаны с устойчивостью бактерий к антибиотикам. Эксперты прогнозируют, что если не принять срочных мер, к 2050 году этот показатель вырастет до 1,91 миллиона.
Ключевыми причинами кризиса названы неправильное использование антибиотиков как в медицине, так и в животноводстве, отсутствие быстрой диагностики и вакцин, а также пробелы в наблюдении. Особую озабоченность вызывает повсеместное применение антибиотиков на фермах, что приводит к появлению устойчивых бактерий, таких как Salmonella, передающихся от животных к человеку.
При этом основной удар приходится на страны с низким и средним уровнем дохода. Фармацевтические компании неохотно инвестируют в разработку новых антибиотиков для бедных регионов из-за низкой прибыльности, создавая порочный круг.
Ответ на пост «История избиения в колледже»77
Самое поганое во всех историях про травлю, что обидчикам ничего не возвращается бумерангом. Это только в книжках и кино такие в конце истории получают по заслугам, а в жизни вчерашняя девочка, которая заливала тебе клей в портфель, подстрекала мальчишек спрятать твои вещи, в открытую, при учителей, издевалась над тобой, сегодня не спившаяся алкоголичка у мусорного бака, а жена богатого и любящего мужа, с которым они растят троих детей.
Ответ на пост «Продолжаем воскрешать жанр анекдотов»1975
Пошли три охотника на охоту, у двоих с собой была водка, а у третьего не
было. Ну он и говорит мужикам: "Вы завязываете мне глаза, даете любую
дичь, а я угадываю кто это, возраст и чем убита. Если угадаю, вы мне
наливаете стакан водки..." Дают ему зайца. Он пощупал и говорит: "Заяц,
возраст 5 лет, убит ножом". Налили стакан. Дают лису. Он пощупал и
говорит: "Лиса бурая, возраст 10 лет, убита винтовкой". Налили стакан.
Дают Кабана. Он пощупал и говорит: "Кабан дикий, возраст 15 лет, убит с
ружья!". Так продолжалось всю охоту... Утром встречаются ихние жены.
Первая говорит: "Бабоньки представьте, муж ушел на охоту с водкой,
пришел без водки и трезвый". Вторая говорит: "У меня тоже самое". Третья
говорит: "Вы представляете, мой ушел без водки, пришел пьяный в жопу,
всю ночь щупал меня между ног и бормотал: "Ёж, 42 года, убит топором в
спину"